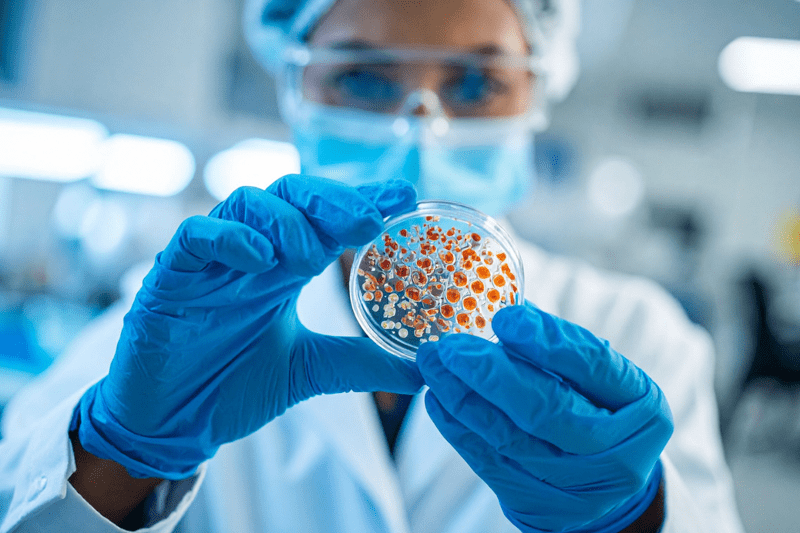

Biotest Project: a true example of building Meaningful Connections
International teamwork with real impact.
At QbD Group, we believe that strong connections drive strong results. Whether you're working side by side or across borders, it's about teaming up, sharing expertise, and supporting one another. That’s exactly what's happening in our recent project with Biotest AG - a true example of what meaningful connections look like in real life.
The challenge
Biotest AG, a biotechnology company near Frankfurt specializing in plasma protein therapies, needed support with their manufacturing operations.
To stay on schedule, they called on QbD Group to provide hands-on expertise and support, allowing their internal team to focus on root cause analysis and ongoing quality challenges.
Our approach
We brought together a team of 7 Quality Assurance (QA) experts from Belgium, the Netherlands, and Germany - including 4 QbD Group consultants - to work on-site at Biotest’s facility in Dreieich.
With a clear target of 2.5 deviation closures per person per week, the team jumped into action after just one month of training. Working closely with Biotest’s production team, they are focusing on:
- On-site support for fast, efficient deviation handling
- Seamless collaboration with Biotest’s internal teams
- Commitment to timelines and quality standards
Living and working in Germany
To make this project work, several QbD Group colleagues temporarily relocated to Germany. That comes with challenges, but also creates a unique sense of team spirit.

The team found creative solutions along the way, from securing long-term housing through Airbnb to planning regular team dinners. And while each colleague has their own rhythm, everyone makes the effort to stay connected.
“It’s a full schedule. I usually travel on Sunday and head back Thursday afternoon. Others are based here full-time. After a while, eating alone gets old - so we make time to meet up, have dinner, share stories. That social bond keeps us going.” - Ronald Slob, Project Manager (QbD Group)
What made it work
Sure, the project had a bumpy start. Fast onboarding meant some early misalignment around scope, housing, and internal communication. But once on the ground, the team made it work thanks in part to strong local support from Biotest and a tightly knit QbD Group crew.

Quality Assurance, Operations, and Sales all play a role. And despite different personalities and backgrounds, the team quickly found its groove. It’s that mix of shared purpose, trust, and good energy that makes the difference.
Why it matters
Projects like this highlight what it really means to work at QbD Group. We don’t just place consultants - we build TEAMS. We grow together. And we make sure people feel supported, wherever they are.
Working at QbD Group means joining a strong, international network of life sciences experts. Our ecosystem - inside and outside QbD Group - gives you room to explore, grow, and connect in ways that matter. Because we know that great work happens when people bring out the best in each other.
Want to be part of something bigger?
Join QbD Group and work with passionate experts across borders and disciplines. Experience how meaningful connections make all the difference for our clients and for your career!
👉 Check out our open positions
👉 More about Meaningful Connections at QbD Group